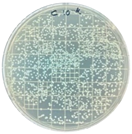
Polymers 17 00325 i005
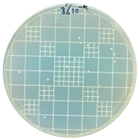
Polymers 17 00325 i007
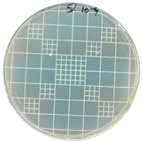
Polymers 17 00325 i008

In Situ Reactive Extrusion of LDPE Films with Methacrylated Pyrogallol for Antimicrobial and Antioxidant Active Packaging
Abstract
1. Introduction
2. Materials and Methods
2.1. Materials
2.2. Synthesis of PGMC Monomer
2.3. Reactive Extrusion of LDPE-g-PGMC
2.4. Characterization
2.5. Statistical Analysis
3. Results
3.1. Chemical Structure
| Sample | Peak (cm−1) | References |
|---|---|---|
| PGMC | 3384 (OH stretching); 2932, 2886 (-CH3 & -CH2); 1702 (C=O); 1603, 944, 806 (C=C); 1477 (C-H); 1295 (C-C); 1164 (C-O-C); 1012 (C-O) | [33,37,38,39] |
| LDPE | 2915 (asymmetric C-H); 2847 (symmetric C-H); 1463 (C-H); 1365 (-CH3 bending); 719 (CH2 rocking vibration) | [32,40,41] |
| LDPE-g-PGMC | 2915 (asymmetric C-H); 2847(symmetric C-H); 1738 (C=O); 1463 (C-H); 1365 (-CH3 bending); 1217 (C-O); 719 (CH2 rocking vibration) | [34,42] |
3.2. Thermal Properties
3.3. Film Density
3.4. Mechanical Properties
3.5. Contact Angle
3.6. Barrier Properties
3.7. Antimicrobial Properties
3.8. Antioxidant Capacity
4. Conclusions
Author Contributions
Funding
Institutional Review Board Statement
Data Availability Statement
Conflicts of Interest
References
- Coles, R.; McDowell, D. Food Packaging Technology; Coles, R., McDowell, D., Kirwan, M.J., Eds.; Wiley-Blackwell: Hoboken, NJ, USA, 2009; ISBN 978-1-405-14771-2. [Google Scholar]
- García-García, R.; Searle, S.S. Preservatives: Food Use. In Encyclopedia of Food and Health; Elsevier: Amsterdam, The Netherlands, 2016; pp. 505–509. [Google Scholar]
- Rifna, E.J.; Dwivedi, M.; Chauhan, O.P. Role of Water Activity in Food Preservation. In Advances in Food Chemistry; Springer Nature: Singapore, 2022; pp. 39–64. [Google Scholar]
- Rooney, M.L. Introduction to Active Food Packaging Technologies. In Innovations in Food Packaging; Elsevier: Amsterdam, The Netherlands, 2005; pp. 63–79. [Google Scholar]
- Singh, A.K.; Ramakanth, D.; Kumar, A.; Lee, Y.S.; Gaikwad, K.K. Active Packaging Technologies for Clean Label Food Products: A Review. J. Food Meas. Charact. 2021, 15, 4314–4324. [Google Scholar] [CrossRef]
- Vasile, C.; Pascu, M. Practical Guide to Polyethylene; RAPRA Technology: Shrewsbury, UK, 2005; ISBN 978-1-85957-493-5. [Google Scholar]
- Mooninta, S.; Poompradub, S.; Prasassarakich, P. Packaging Film of PP/LDPE/PLA/Clay Composite: Physical, Barrier and Degradable Properties. J. Polym. Environ. 2020, 28, 3116–3128. [Google Scholar] [CrossRef]
- Shemesh, R.; Krepker, M.; Goldman, D.; Danin-Poleg, Y.; Kashi, Y.; Nitzan, N.; Vaxman, A.; Segal, E. Antibacterial and Antifungal LDPE Films for Active Packaging. Polym. Adv. Technol. 2015, 26, 110–116. [Google Scholar] [CrossRef]
- Barbosa-Pereira, L.; Angulo, I.; Lagarón, J.M.; Paseiro-Losada, P.; Cruz, J.M. Development of New Active Packaging Films Containing Bioactive Nanocomposites. Innov. Food Sci. Emerg. Technol. 2014, 26, 310–318. [Google Scholar] [CrossRef]
- Joung, J.; Boonsiriwit, A.; Kim, M.; Lee, Y.S. Application of Ethylene Scavenging Nanocomposite Film Prepared by Loading Potassium Permanganate-Impregnated Halloysite Nanotubes into Low-Density Polyethylene as Active Packaging Material for Fresh Produce. LWT 2021, 145, 111309. [Google Scholar] [CrossRef]
- Sängerlaub, S.; Seibel, K.; Miesbauer, O.; Pant, A.; Kiese, S.; Rodler, N.; Schmid, M.; Müller, K. Functional Properties of Foamed and/or Stretched Polypropylene-Films Containing Sodium Chloride Particles for Humidity Regulation. Polym. Test. 2018, 65, 339–351. [Google Scholar] [CrossRef]
- Aydogdu, A.; Yildiz, E.; Aydogdu, Y.; Sumnu, G.; Sahin, S.; Ayhan, Z. Enhancing Oxidative Stability of Walnuts by Using Gallic Acid Loaded Lentil Flour Based Electrospun Nanofibers as Active Packaging Material. Food Hydrocoll. 2019, 95, 245–255. [Google Scholar] [CrossRef]
- Wang, L.-F.; Rhim, J.-W. Grapefruit Seed Extract Incorporated Antimicrobial LDPE and PLA Films: Effect of Type of Polymer Matrix. LWT 2016, 74, 338–345. [Google Scholar] [CrossRef]
- Flórez, M.; Guerra-Rodríguez, E.; Cazón, P.; Vázquez, M. Chitosan for Food Packaging: Recent Advances in Active and Intelligent Films. Food Hydrocoll. 2022, 124, 107328. [Google Scholar] [CrossRef]
- Gaikwad, K.K.; Singh, S.; Negi, Y.S. Ethylene Scavengers for Active Packaging of Fresh Food Produce. Environ. Chem. Lett. 2020, 18, 269–284. [Google Scholar] [CrossRef]
- Releasing Systems in Active Food Packaging; Jafari, S.M., Silva, A.S., Eds.; Springer International Publishing: Cham, Switzerland, 2022; ISBN 978-3-030-90298-8. [Google Scholar]
- Bigham, A.; Rahimkhoei, V.; Abasian, P.; Delfi, M.; Naderi, J.; Ghomi, M.; Dabbagh Moghaddam, F.; Waqar, T.; Nuri Ertas, Y.; Sharifi, S.; et al. Advances in Tannic Acid-Incorporated Biomaterials: Infection Treatment, Regenerative Medicine, Cancer Therapy, and Biosensing. Chem. Eng. J. 2022, 432, 134146. [Google Scholar] [CrossRef]
- Ahn, B.J.; Gaikwad, K.K.; Lee, Y.S. Characterization and Properties of LDPE Film with Gallic-Acid-Based Oxygen Scavenging System Useful as a Functional Packaging Material. J. Appl. Polym. Sci. 2016, 133. [Google Scholar] [CrossRef]
- Promsorn, J.; Harnkarnsujarit, N. Pyrogallol Loaded Thermoplastic Cassava Starch Based Films as Bio-Based Oxygen Scavengers. Ind. Crops Prod. 2022, 186, 115226. [Google Scholar] [CrossRef]
- Woranuch, S.; Yoksan, R. Eugenol-Loaded Chitosan Nanoparticles: II. Application in Bio-Based Plastics for Active Packaging. Carbohydr. Polym. 2013, 96, 586–592. [Google Scholar] [CrossRef]
- Salmas, C.E.; Giannakas, A.E.; Baikousi, M.; Leontiou, A.; Siasou, Z.; Karakassides, M.A. Development of Poly(L-Lactic Acid)/Chitosan/Basil Oil Active Packaging Films via a Melt-Extrusion Process Using Novel Chitosan/Basil Oil Blends. Processes 2021, 9, 88. [Google Scholar] [CrossRef]
- Panrong, T.; Karbowiak, T.; Harnkarnsujarit, N. Thermoplastic Starch and Green Tea Blends with LLDPE Films for Active Packaging of Meat and Oil-Based Products. Food Packag. Shelf Life 2019, 21, 100331. [Google Scholar] [CrossRef]
- Giannakas, A.E.; Salmas, C.E.; Leontiou, A.; Baikousi, M.; Moschovas, D.; Asimakopoulos, G.; Zafeiropoulos, N.E.; Avgeropoulos, A. Synthesis of a Novel Chitosan/Basil Oil Blend and Development of Novel Low Density Poly Ethylene/Chitosan/Basil Oil Active Packaging Films Following a Melt-Extrusion Process for Enhancing Chicken Breast Fillets Shelf-Life. Molecules 2021, 26, 1585. [Google Scholar] [CrossRef] [PubMed]
- Martey, S.; Addison, B.; Wilson, N.; Tan, B.; Yu, J.; Dorgan, J.R.; Sobkowicz, M.J. Hybrid Chemomechanical Plastics Recycling: Solvent-free, High-Speed Reactive Extrusion of Low-Density Polyethylene. ChemSusChem 2021, 14, 4280–4290. [Google Scholar] [CrossRef] [PubMed]
- Li, J.; Baker, T.; Sacripante, G.G.; Lawton, D.J.W.; Marway, H.S.; Zhang, H.; Thompson, M.R. Solvent-Free Production of Thermoplastic Lignocellulose from Wood Pulp by Reactive Extrusion. Carbohydr. Polym. 2021, 270, 118361. [Google Scholar] [CrossRef]
- Hu, G.H.; Khalfalla, Y.; Benyounis, K.Y. Reactive Polymer Processing: Fundamentals of REX. In Reference Module in Materials Science and Materials Engineering; Elsevier: Amsterdam, The Netherlands, 2016. [Google Scholar]
- Janssen, L.P.B.M. Reactive Extrusion Systems; CRC Press: Boca Raton, FL, USA, 2004; ISBN 9780429215018. [Google Scholar]
- Wagner, J.R.; Mount, E.M.; Giles, H.F. Processing Conditions. In Extrusion; Elsevier: Amsterdam, The Netherlands, 2014; pp. 181–192. [Google Scholar]
- Sadeghi, K.; Jee, H.-W.; Paeng, K.-J.; Seo, J. Photografting of Conducting Polymer onto Polymeric Substrate as Non-Migratory Antioxidant Packaging. React. Funct. Polym. 2021, 158, 104792. [Google Scholar] [CrossRef]
- Li, D.; Zhou, L.; Wang, X.; He, L.; Yang, X. Effect of Crystallinity of Polyethylene with Different Densities on Breakdown Strength and Conductance Property. Materials 2019, 12, 1746. [Google Scholar] [CrossRef] [PubMed]
- JIS Z 2801:2010; Antibacterial Products—Test For Antibacterial Activity And Efficacy. Japanese Standards Association: Tokyo, Japan, 20 December 2010.
- Smith, B.C. The Infrared Spectra of Polymers II: Polyethylene. Spectroscopy 2021, 36, 24–29. [Google Scholar] [CrossRef]
- Liu, R.; Zheng, J.; Guo, R.; Luo, J.; Yuan, Y.; Liu, X. Synthesis of New Biobased Antibacterial Methacrylates Derived from Tannic Acid and Their Application in UV-Cured Coatings. Ind. Eng. Chem. Res. 2014, 53, 10835–10840. [Google Scholar] [CrossRef]
- Rocha, J.E.; Guedes, T.T.A.M.; Bezerra, C.F.; Costa, M.d.S.; Campina, F.F.; de Freitas, T.S.; Sousa, A.K.; Sobral Souza, C.E.; Silva, M.K.N.; Lobo, Y.M.; et al. FTIR Analysis of Pyrogallol and Phytotoxicity-Reductive Effect against Mercury Chloride. Environ. Geochem. Health 2021, 43, 2433–2442. [Google Scholar] [CrossRef] [PubMed]
- Feng, L.; Yang, H.; Dong, X.; Lei, H.; Chen, D. PH-Sensitive Polymeric Particles as Smart Carriers for Rebar Inhibitors Delivery in Alkaline Condition. J. Appl. Polym. Sci. 2018, 135, 45886. [Google Scholar] [CrossRef]
- Lopera-Valle, A.; Elias, A. Amine Responsive Poly(Lactic Acid) (PLA) and Succinic Anhydride (SAh) Graft-Polymer: Synthesis and Characterization. Polymers 2019, 11, 1466. [Google Scholar] [CrossRef]
- Liu, R.; Zhu, J.; Luo, J.; Liu, X. Synthesis and Application of Novel UV-Curable Hyperbranched Methacrylates from Renewable Natural Tannic Acid. Prog. Org. Coat. 2014, 77, 30–37. [Google Scholar] [CrossRef]
- Tan, K.; Liu, R.; Luo, J.; Zhu, Y.; Wei, W.; Liu, X. Tannic Acid Functionalized UV-Curable Carbon Nanotube: Effective Reinforcement of Acrylated Epoxidized Soybean Oil Coating. Prog. Org. Coat. 2019, 130, 214–220. [Google Scholar] [CrossRef]
- Handique, J.; Gogoi, J.; Nath, J.; Dolui, S.K. Synthesis of Self-Healing Bio-Based Tannic Acid-Based Methacrylates by Thermoreversible Diels–Alder Reaction. Polym. Eng. Sci. 2020, 60, 140–150. [Google Scholar] [CrossRef]
- Hadi, J.; Najmuldeen, F.; Ahmed, I. Quality Restoration of Waste Polyolefin Plastic Material through the Dissolution-Reprecipitation Technique. Chem. Ind. Chem. Eng. Q. 2014, 20, 163–170. [Google Scholar] [CrossRef]
- Rajandas, H.; Parimannan, S.; Sathasivam, K.; Ravichandran, M.; Su Yin, L. A Novel FTIR-ATR Spectroscopy Based Technique for the Estimation of Low-Density Polyethylene Biodegradation. Polym. Test. 2012, 31, 1094–1099. [Google Scholar] [CrossRef]
- Smith, B.C. Infrared Spectroscopy of Polymers X: Polyacrylates. Spectroscopy 2023, 38, 10–14. [Google Scholar] [CrossRef]
- Wang, L.; Brink, J.J.; Liu, Y.; Herring, A.M.; Ponce-González, J.; Whelligan, D.K.; Varcoe, J.R. Non-Fluorinated Pre-Irradiation-Grafted (Peroxidated) LDPE-Based Anion-Exchange Membranes with High Performance and Stability. Energy Environ. Sci. 2017, 10, 2154–2167. [Google Scholar] [CrossRef]
- Kuwabara, K.; Kaji, H.; Horii, F.; Bassett, D.C.; Olley, R.H. Solid-State 13C NMR Analyses of the Crystalline−Noncrystalline Structure for Metallocene-Catalyzed Linear Low-Density Polyethylene. Macromolecules 1997, 30, 7516–7521. [Google Scholar] [CrossRef]
- Jiang, W.; Fischer, G.; Girmay, Y.; Irgum, K. Zwitterionic Stationary Phase with Covalently Bonded Phosphorylcholine Type Polymer Grafts and Its Applicability to Separation of Peptides in the Hydrophilic Interaction Liquid Chromatography Mode. J. Chromatogr. A 2006, 1127, 82–91. [Google Scholar] [CrossRef]
- Doğan, Ö.M.; Kayacan, İ. Pyrolysis of Low and High Density Polyethylene. Part II: Analysis of Liquid Products Using FTIR and NMR Spectroscopy. Energy Sources Part A Recovery Util. Environ. Eff. 2008, 30, 392–400. [Google Scholar] [CrossRef]
- Wu, Y.; Fei, M.; Chen, T.; Qiu, R.; Liu, W. Biocomposites from Bamboo Fibers and Palm Oil-Based Thermosets: Effects of Natural Phenolic Cross-Linkers. Compos. Commun. 2020, 22, 100489. [Google Scholar] [CrossRef]
- Al-Odayni, A.-B.; Saeed, W.S.; Ahmed, A.Y.B.H.; Alrahlah, A.; Al-Kahtani, A.; Aouak, T. New Monomer Based on Eugenol Methacrylate, Synthesis, Polymerization and Copolymerization with Methyl Methacrylate–Characterization and Thermal Properties. Polymers 2020, 12, 160. [Google Scholar] [CrossRef] [PubMed]
- Hamulić, D.; Rodič, P.; Poberžnik, M.; Jereb, M.; Kovač, J.; Milošev, I. The Effect of the Methyl and Ethyl Group of the Acrylate Precursor in Hybrid Silane Coatings Used for Corrosion Protection of Aluminium Alloy 7075-T6. Coatings 2020, 10, 172. [Google Scholar] [CrossRef]
- Rodič, P.; Milošev, I.; Lekka, M.; Andreatta, F.; Fedrizzi, L. Corrosion Behaviour and Chemical Stability of Transparent Hybrid Sol-Gel Coatings Deposited on Aluminium in Acidic and Alkaline Solutions. Prog. Org. Coat. 2018, 124, 286–295. [Google Scholar] [CrossRef]
- Hammer, P.; dos Santos, F.C.; Cerrutti, B.M.; Pulcinelli, S.H.; Santilli, C.V. Highly Corrosion Resistant Siloxane-Polymethyl Methacrylate Hybrid Coatings. J. Solgel. Sci. Technol. 2012, 63, 266–274. [Google Scholar] [CrossRef]
- Lankhorst, P.; van Rijn, J.; Duchateau, A. One-Dimensional 13C NMR Is a Simple and Highly Quantitative Method for Enantiodiscrimination. Molecules 2018, 23, 1785. [Google Scholar] [CrossRef]
- Salarian, M.; Xu, W.Z.; Biesinger, M.C.; Charpentier, P.A. Synthesis and Characterization of Novel TiO2-Poly(Propylene Fumarate) Nanocomposites for Bone Cementation. J. Mater. Chem. B 2014, 2, 5145–5156. [Google Scholar] [CrossRef]
- Wawer, I.; Zielinska, A. 13C-CP-MAS-NMR Studies of Flavonoids. I. Solid-State Conformation of Quercetin, Quercetin 5′-Sulphonic Acid and Some Simple Polyphenols. Solid State Nucl. Magn. Reson. 1997, 10, 33–38. [Google Scholar] [CrossRef] [PubMed]
- Khan, M.; Enkelmann, V.; Brunklaus, G. Solid-State NMR and X-ray Analysis of Structural Transformations in O−H···N Heterosynthons Formed by Hydrogen-Bond-Mediated Molecular Recognition. J. Org. Chem. 2009, 74, 2261–2270. [Google Scholar] [CrossRef] [PubMed]
- Madani, M. Structure, Optical and Thermal Decomposition Characters of LDPE Graft Copolymers Synthesized by Gamma Irradiation. Curr. Appl. Phys. 2011, 11, 70–76. [Google Scholar] [CrossRef]
- Toi, K.; Igarashi, K.; Takuda, T. Effect of Styrene Grafting on Diffusion and Solubility of Gases in Polyethylene. J. Appl. Polym. Sci. 1976, 20, 703–714. [Google Scholar] [CrossRef]
- Sadeghi, K.; Seo, J. Photografting of P-Anisidine-Glycidyl Methacrylate onto Polymeric Substrate for Developing Free-Radical Scavenging Films. Prog. Org. Coat. 2020, 149, 105925. [Google Scholar] [CrossRef]
- Sadeghi, K.; Seo, J. Facile Approach to the Solid Support Photografting Coating of Citric Acid as a Novel Biomimetic Iron Chelator Film. Surf. Interfaces 2021, 22, 100814. [Google Scholar] [CrossRef]
- Wang, D.; Yang, B.; Chen, Q.-T.; Chen, J.; Su, L.-F.; Chen, P.; Zheng, Z.-Z.; Miao, J.-B.; Qian, J.-S.; Xia, R.; et al. A Facile Evaluation on Melt Crystallization Kinetics and Thermal Properties of Low-Density Polyethylene (LDPE)/Recycled Polyethylene Terephthalate (RPET) Blends. Adv. Ind. Eng. Polym. Res. 2019, 2, 126–135. [Google Scholar] [CrossRef]
- Coscia, U.; Longo, A.; Palomba, M.; Sorrentino, A.; Barucca, G.; Di Bartolomeo, A.; Urban, F.; Ambrosone, G.; Carotenuto, G. Influence of the Thermomechanical Characteristics of Low-Density Polyethylene Substrates on the Thermoresistive Properties of Graphite Nanoplatelet Coatings. Coatings 2021, 11, 332. [Google Scholar] [CrossRef]
- Alexander, L. X-Ray Diffraction Methods in Polymer Science. J. Mater. Sci. 1971, 6, 93. [Google Scholar] [CrossRef]
- Benabid, F.; Kharchi, N.; Zouai, F.; Mourad, A.-H.I.; Benachour, D. Impact of Co-Mixing Technique and Surface Modification of ZnO Nanoparticles Using Stearic Acid on Their Dispersion into HDPE to Produce HDPE/ZnO Nanocomposites. Polym. Polym. Compos. 2019, 27, 389–399. [Google Scholar] [CrossRef]
- Luo, S.; Cao, J.; McDonald, A.G. Interfacial Improvements in a Green Biopolymer Alloy of Poly(3-Hydroxybutyrate-Co-3-Hydroxyvalerate) and Lignin via in Situ Reactive Extrusion. ACS Sustain. Chem. Eng. 2016, 4, 3465–3476. [Google Scholar] [CrossRef]
- Wu, X.; Pu, L.; Xu, Y.; Shi, J.; Liu, X.; Zhong, Z.; Luo, S.-N. Deformation of High Density Polyethylene by Dynamic Equal-Channel-Angular Pressing. RSC Adv. 2018, 8, 22583–22591. [Google Scholar] [CrossRef]
- Wang, C.-C.; Wu, K.-H.; Lo, C.-T. Chain Architecture and Hydrogen Bonding Induced Co-Ordering and Segregation of Block Copolymer/Graft Copolymer Blends. Macromolecules 2019, 52, 3210–3221. [Google Scholar] [CrossRef]
- Garro^Galvez, J.M.; Fechtal, M.; Riedl, B. Gallic Acid as a Model of Tannins in Condensation with Formaldehyde. Thermochim. Acta 1996, 274, 149–163. [Google Scholar] [CrossRef]
- Gaikwad, K.K.; Singh, S.; Lee, Y.S. A Pyrogallol-Coated Modified LDPE Film as an Oxygen Scavenging Film for Active Packaging Materials. Prog. Org. Coat. 2017, 111, 186–195. [Google Scholar] [CrossRef]
- Trovati, G.; Sanches, E.A.; Neto, S.C.; Mascarenhas, Y.P.; Chierice, G.O. Characterization of Polyurethane Resins by FTIR, TGA, and XRD. J. Appl. Polym. Sci. 2010, 115, 263–268. [Google Scholar] [CrossRef]
- Cangemi, J.M.; Claro Neto, S.; Chierice, G.O.; Santos, A.M. dos Study of the Biodegradation of a Polymer Derived from Castor Oil by Scanning Electron Microscopy, Thermogravimetry and Infrared Spectroscopy. Polímeros 2006, 16, 129–135. [Google Scholar] [CrossRef]
- Boyron, O.; Marre, T.; Delauzun, A.; Cozic, R.; Boisson, C. An Advanced Technique for Linear Low-Density Polyethylene Composition Determination: TGA–IST16–GC–MS Coupling. Macromol. Chem. Phys. 2019, 220, 1900162. [Google Scholar] [CrossRef]
- McGarry, K.; Zilberman, J.; Hull, T.R.; Woolley, W.D. Decomposition and Combustion of EVA and LDPE Alone and When Fire Retarded with ATH. Polym. Int. 2000, 49, 1193–1198. [Google Scholar] [CrossRef]
- Bockhorn, H.; Hornung, A.; Hornung, U.; Schawaller, D. Kinetic Study on the Thermal Degradation of Polypropylene and Polyethylene. J. Anal. Appl. Pyrolysis 1999, 48, 93–109. [Google Scholar] [CrossRef]
- Awad, S.A. Mechanical and Thermal Characterisations of Low-Density Polyethylene/Nanoclay Composites. Polym. Polym. Compos. 2021, 29, 1325–1332. [Google Scholar] [CrossRef]
- Singh, S.K.; Tambe, S.P.; Samui, A.B.; Raja, V.S.; Kumar, D. Maleic Acid Grafted Low Density Polyethylene for Thermally Sprayable Anticorrosive Coatings. Prog. Org. Coat. 2006, 55, 20–26. [Google Scholar] [CrossRef]
- Videira-Quintela, D.; Guillén, F.; Martin, O.; Montalvo, G. Antibacterial LDPE Films for Food Packaging Application Filled with Metal-Fumed Silica Dual-Side Fillers. Food Packag. Shelf Life 2022, 31, 100772. [Google Scholar] [CrossRef]
- Gaikwad, K.K.; Singh, S.; Lee, Y.S. Antimicrobial and Improved Barrier Properties of Natural Phenolic Compound-Coated Polymeric Films for Active Packaging Applications. J. Coat. Technol. Res. 2019, 16, 147–157. [Google Scholar] [CrossRef]
- Tharakan, S.A.; Muthusamy, S. The Effects of Long and Bulky Aromatic Pendent Groups with Flexible Linkages on the Thermal, Mechanical and Electrical Properties of the Polyimides and Their Nanocomposites with Functionalized Silica. RSC Adv. 2021, 11, 16645–16660. [Google Scholar] [CrossRef] [PubMed]
- Garcia, D.; Starkweather, H.W. Hydrogen Bonding in Nylon 66 and Model Compounds. J. Polym. Sci. Polym. Phys. Ed. 1985, 23, 537–555. [Google Scholar] [CrossRef]
- Njoroge, W.K.; Wöltgens, H.-W.; Wuttig, M. Density Changes upon Crystallization of Ge2Sb2.04Te4.74 Films. J. Vac. Sci. Technol. A Vac. Surf. Film. 2002, 20, 230–233. [Google Scholar] [CrossRef]
- Mohanty, A.D.; Bae, C. Transition Metal-Catalyzed Functionalization of Polyolefins Containing CC, CC, and CH Bonds. Adv. Organomet. Chem. 2015, 64, 1–39. [Google Scholar]
- Balani, K.; Verma, V.; Agarwal, A.; Narayan, R. Biosurfaces; John Wiley & Sons, Inc.: Hoboken, NJ, USA, 2014; ISBN 9781118950623. [Google Scholar]
- Shikata, T.; Okuzono, M. Are All Polar Molecules Hydrophilic? Hydration Numbers of Ketones and Esters in Aqueous Solution. J. Phys. Chem. B 2013, 117, 7718–7723. [Google Scholar] [CrossRef] [PubMed]
- Ioelovich, M. Adjustment of Hydrophobic Properties of Cellulose Materials. Polymers 2021, 13, 1241. [Google Scholar] [CrossRef]
- Kim, H.; Panda, P.K.; Sadeghi, K.; Seo, J. Poly (Vinyl Alcohol)/Hydrothermally Treated Tannic Acid Composite Films as Sustainable Antioxidant and Barrier Packaging Materials. Prog. Org. Coat. 2023, 174, 107305. [Google Scholar] [CrossRef]
- Metz, S.J.; Mulder, M.H.V.; Wessling, M. Gas-Permeation Properties of Poly(Ethylene Oxide) Poly(Butylene Terephthalate) Block Copolymers. Macromolecules 2004, 37, 4590–4597. [Google Scholar] [CrossRef]
- Zhu, W.; Chen, J.; Dong, Q.; Luan, D.; Tao, N.; Deng, S.; Wang, L.; Hao, Y.; Li, L. Development of Organic-Inorganic Hybrid Antimicrobial Materials by Mechanical Force and Application for Active Packaging. Food Packag. Shelf Life 2023, 37, 101060. [Google Scholar] [CrossRef]
- Kim, E.-Y.; Lee, J.-H.; Lee, D.-J.; Lee, Y.-H.; Lee, J.-H.; Kim, H.-D. Synthesis and Properties of Highly Hydrophilic Waterborne Polyurethane-Ureas Containing Various Hardener Content for Waterproof Breathable Fabrics. J. Appl. Polym. Sci. 2013, 129, 1745–1751. [Google Scholar] [CrossRef]
- Cynthia; Florence, I.; Sutanto, H.; Darmawan, A. Antibacterial and Antioxidant Activities of Pyrogallol and Synthetic Pyrogallol Dimer. Res. J. Chem. Environ. 2018, 22, 39–47. [Google Scholar]
- Chew, Y.-L.; Arasi, C.; Goh, J.-K. Pyrogallol Induces Antimicrobial Effect and Cell Membrane Disruption on Methicillin-Resistant Staphylococcus Aureus (MRSA). Curr. Bioact. Compd. 2022, 18, 38–46. [Google Scholar] [CrossRef]
- Atala, E.; Aspée, A.; Speisky, H.; Lissi, E.; López-Alarcón, C. Antioxidant Capacity of Phenolic Compounds in Acidic Medium: A Pyrogallol Red-Based ORAC (Oxygen Radical Absorbance Capacity) Assay. J. Food Compos. Anal. 2013, 32, 116–125. [Google Scholar] [CrossRef]
- Li, X. Improved Pyrogallol Autoxidation Method: A Reliable and Cheap Superoxide-Scavenging Assay Suitable for All Antioxidants. J. Agric. Food Chem. 2012, 60, 6418–6424. [Google Scholar] [CrossRef] [PubMed]
- Peng, Y.; Wu, Y.; Li, Y. Development of Tea Extracts and Chitosan Composite Films for Active Packaging Materials. Int. J. Biol. Macromol. 2013, 59, 282–289. [Google Scholar] [CrossRef] [PubMed]
- Zhu, X.; Lee, D.S.; Yam, K.L. Release Property and Antioxidant Effectiveness of Tocopherol-Incorporated LDPE/PP Blend Films. Food Addit. Contam. Part A 2011, 29, 461–468. [Google Scholar] [CrossRef] [PubMed]
- Ohm, V.A.; Stöckmann, H.; Schwarz, K. The More—The Better? Estimating the Inhibitory Activity of Alpha-Tocopherol towards Lipid Oxidation. J. Plant Physiol. 2005, 162, 785–789. [Google Scholar] [CrossRef] [PubMed]










| Name | LDPE Resin (g) | Benzoyl Peroxide (g) | PGMC (g) | Film Thickness (mm) |
|---|---|---|---|---|
| LDPE | 300 | 0 | 0 | 0.075 ± 0.001 |
| LDPE-g-PGMC-1 | 300 | 1.5 | 3 | 0.083 ± 0.001 |
| LDPE-g-PGMC-3 | 300 | 1.5 | 9 | 0.077 ± 0.002 |
| LDPE-g-PGMC-5 | 300 | 1.5 | 15 | 0.081 ± 0.005 |
| Samples | Lattice Plane | 2θ (°) | FWHM (°) | Crystallite Size (Å) | D-Spacing (Å) |
|---|---|---|---|---|---|
| LDPE | 110 | 21.3 | 0.536 | 1.5 | 4.2 |
| 020 | 36.4 | 0.636 | 1.3 | 2.5 | |
| LDPE-g-PGMC-1 | 110 | 21.3 | 0.574 | 1.4 | 4.2 |
| 020 | 36.4 | 0.516 | 1.6 | 2.5 | |
| LDPE-g-PGMC-3 | 110 | 21.3 | 0.546 | 1.5 | 4.2 |
| 020 | 36.4 | 0.484 | 1.7 | 2.5 | |
| LDPE-g-PGMC-5 | 110 | 21.3 | 0.554 | 1.5 | 4.2 |
| 020 | 36.4 | 0.498 | 1.7 | 2.5 |
| Samples | Tm (°C) | ∆Hm (J/g) | Tc (°C) | ∆Hc (J/g) | Xc (%) |
|---|---|---|---|---|---|
| LDPE | 109.4 ± 0.1 | 97.1 ± 1.8 | 96.2 ± 0.1 | 68.0 ± 1.0 | 33.1 |
| LDPE-g-PGMC-1 | 109.4 ± 0.2 | 104.9 ± 2.8 | 96.2 ± 0.1 | 70.1 ± 3.8 | 35.8 |
| LDPE-g-PGMC-3 | 109.4 ± 0.1 | 105.8 ± 0.9 | 96.2 ± 0.1 | 71.1 ± 2.2 | 36.1 |
| LDPE-g-PGMC-5 | 109.6 ± 0.2 | 105.9 ± 1.4 | 96.1 ± 0.1 | 70.0 ± 1.4 | 36.2 |
| Samples | Density (g/cm3) | E 1 (MPa) | TS 2 (MPa) | EB 3 (%) | OTR (cc/m2·Day) | WVTR |
|---|---|---|---|---|---|---|
| (g/m2·Day) | ||||||
| LDPE | 0.857 ± 0.03 b | 114.3 ± 5.9 b | 17.9 ± 0.6 c | 188.2 ± 6.1 a | 2337 ± 20.4 a | 1.8 ± 0.01 a |
| LDPE-g-PGMC-1 | 0.941 ± 0.03 a | 157.6 ± 6.4 a | 19.5 ± 0.4 b | 163.2 ± 3.4 b | 2030 ± 18.5 b | 1.7 ± 0.02 b |
| LDPE-g-PGMC-3 | 0.962 ± 0.03 a | 169.9 ± 7.1 a | 19.9 ± 1.2 b | 135.4 ± 6.1 c | 1883 ± 44.9 c | 1.7 ± 0.01 b |
| LDPE-g-PGMC-5 | 0.986 ± 0.03 a | 179.1 ± 7.8 a | 22.1 ± 1.1 a | 115.5 ± 0.7 d | 1658 ± 33.0 d | 1.6 ± 0.01 c |
| LDPE | LDPE-g-PGMC-1 | LDPE-g-PGMC-3 | LDPE-g-PGMC-5 | ||
|---|---|---|---|---|---|
| E. coli | Digital image | ![]() | ![]() | ![]() | ![]() |
| Concentration (CFU/mL) | 2.05 × 105 | 2.00 × 10 | 0 | 0 | |
| Reduction (%) | – | 99.99 | 100 | 100 | |
| S. aureus | Digital image | ![]() | ![]() | ![]() | ![]() |
| Concentration (CFU/mL) | 2.25 × 108 | 2.40 × 107 | 7.00 × 106 | 2.00 × 107 | |
| Reduction (%) | – | 89.33 | 96.86 | 99.11 |
Disclaimer/Publisher’s Note: The statements, opinions and data contained in all publications are solely those of the individual author(s) and contributor(s) and not of MDPI and/or the editor(s). MDPI and/or the editor(s) disclaim responsibility for any injury to people or property resulting from any ideas, methods, instructions or products referred to in the content. |
© 2025 by the authors. Licensee MDPI, Basel, Switzerland. This article is an open access article distributed under the terms and conditions of the Creative Commons Attribution (CC BY) license (https://creativecommons.org/licenses/by/4.0/).
Share and Cite
Sulistiawan, S.S.; Sadeghi, K.; Kumar, R.; Kim, D.; Seo, J. In Situ Reactive Extrusion of LDPE Films with Methacrylated Pyrogallol for Antimicrobial and Antioxidant Active Packaging. Polymers 2025, 17, 325. https://doi.org/10.3390/polym17030325
Sulistiawan SS, Sadeghi K, Kumar R, Kim D, Seo J. In Situ Reactive Extrusion of LDPE Films with Methacrylated Pyrogallol for Antimicrobial and Antioxidant Active Packaging. Polymers. 2025; 17(3):325. https://doi.org/10.3390/polym17030325
Chicago/Turabian StyleSulistiawan, Sharifa Salma, Kambiz Sadeghi, Ritesh Kumar, Dowan Kim, and Jongchul Seo. 2025. "In Situ Reactive Extrusion of LDPE Films with Methacrylated Pyrogallol for Antimicrobial and Antioxidant Active Packaging" Polymers 17, no. 3: 325. https://doi.org/10.3390/polym17030325
APA StyleSulistiawan, S. S., Sadeghi, K., Kumar, R., Kim, D., & Seo, J. (2025). In Situ Reactive Extrusion of LDPE Films with Methacrylated Pyrogallol for Antimicrobial and Antioxidant Active Packaging. Polymers, 17(3), 325. https://doi.org/10.3390/polym17030325